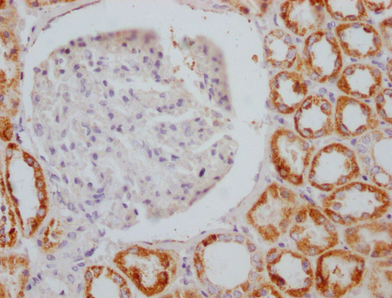
AIFM1重組單克隆抗體

PRODUCT CENTER
特色產(chǎn)品當(dāng)前位置:首頁(yè) > 特色產(chǎn)品
AIFM1既作為NADH氧化還原酶發(fā)揮作用,也作為細(xì)胞凋亡的調(diào)節(jié)因子。在凋亡刺激下,它從線粒體膜間隙釋放到細(xì)胞質(zhì)和細(xì)胞核中,在那里作為一種非caspase依賴途徑中的促凋亡因子發(fā)揮作用。相比之下,在正常的線粒體中,它通過(guò)其NADH氧化還原酶活性發(fā)揮抗凋亡因子的作用。可溶性形式(AIFsol)存在于細(xì)胞核中,可誘導(dǎo)“parthanatos”,即染色體DNA的非caspase依賴性片段化。AIFM1與EIF3G相互作用,從而抑制EIF3機(jī)器和蛋白質(zhì)合成,并激活caspase-7以增強(qiáng)凋亡。在過(guò)氧化氫暴露的細(xì)胞中,AIFM1在非caspase依賴性、細(xì)胞核固縮性細(xì)胞死亡中發(fā)揮關(guān)鍵作用。它以序列非依賴性方式結(jié)合DNA。
AIFM1重組單克隆抗體 [4B2]。未偶聯(lián)。在HEK293F細(xì)胞中制備。
艾美捷Epigentek-AIFM1重組單克隆抗體[4B2]:
貨號(hào):A73694-050
緩沖液:在磷酸鹽緩沖液(pH 7.4,150 mM NaCl,0.02%疊氮化鈉和50%甘油)中的兔IgG。
特異性:人、大鼠
同種型:兔IgG
純化方法:親和層析
免疫原:來(lái)源于人AIF的合成肽段
儲(chǔ)存:收到后,請(qǐng)?jiān)?20°C或-80°C下保存。避免反復(fù)凍融。
替代名稱:凋亡誘導(dǎo)因子1,線粒體(EC 1.1.1.-)(程序性細(xì)胞死亡蛋白8),AIFM1,AIF PDCD8
應(yīng)用:
ELISA、Western Blot(WB)、免疫組化(IHC);推薦稀釋度:WB:1:500-1:5000,IHC:1:50-1:200
圖:使用AIFM1重組單克隆抗體(1:100稀釋度)對(duì)石蠟包埋的人腎組織進(jìn)行染色,實(shí)驗(yàn)在Leica Bond系統(tǒng)上完成。經(jīng)過(guò)脫蠟和水化后,使用檸檬酸緩沖液(pH 6.0)在高壓下進(jìn)行抗原修復(fù)。切片用10%正常山羊血清在室溫下封閉30分鐘,然后在4℃下用一抗(1% BSA)孵育過(guò)夜。一抗通過(guò)山羊抗兔IgG聚合物檢測(cè),該聚合物標(biāo)記有HRP,并使用0.5% DAB進(jìn)行顯色。

微信掃碼在線客服